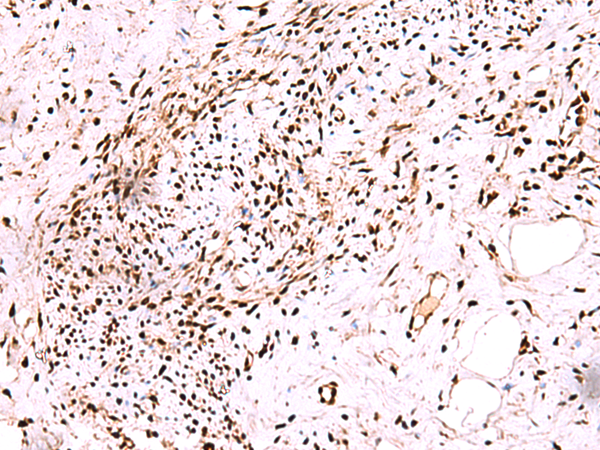

中文名稱:兔抗CDKN1B多克隆抗體
英文名稱: Anti-CDKN1B rabbit polyclonal antibody
別 名: cyclin dependent kinase inhibitor 1B; KIP1; MEN4; CDKN4; MEN1B; P27KIP1
宿 主: Rabbit
抗 原: CDKN1B
反應(yīng)種屬: Human, Mouse
標(biāo) 記 物: Unconjugate
克隆類型: rabbit polyclonal
技術(shù)規(guī)格
|
Background: |
This gene encodes a cyclin-dependent kinase inhibitor, which shares a limited similarity with CDK inhibitor CDKN1A/p21. The encoded protein binds to and prevents the activation of cyclin E-CDK2 or cyclin D-CDK4 complexes, and thus controls the cell cycle progression at G1. The degradation of this protein, which is triggered by its CDK dependent phosphorylation and subsequent ubiquitination by SCF complexes, is required for the cellular transition from quiescence to the proliferative state. Mutations in this gene are associated with multiple endocrine neoplasia type IV (MEN4). |
|
Applications: |
ELISA, IHC |
|
Name of antibody: |
CDKN1B |
|
Immunogen: |
Fusion protein of human CDKN1B |
|
Full name: |
cyclin dependent kinase inhibitor 1B |
|
Synonyms: |
KIP1; MEN4; CDKN4; MEN1B; P27KIP1 |
|
SwissProt: |
P46527 |
|
ELISA Recommended dilution: |
5000-10000 |
|
IHC positive control: |
Human cervical cancer and Human ovarian cancer |
|
IHC Recommend dilution: |
50-300 |

購(gòu)物車
幫助
021-54845833/15800441009
